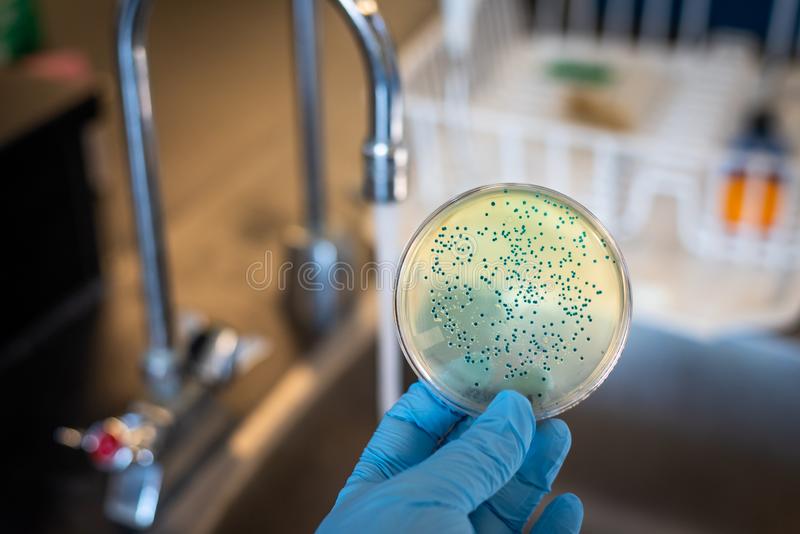

De acuerdo con lo informado durante la conferencia de prensa del lunes 5 de septiembre, el Departamento de Obras Públicas (DPW, por sus siglas en inglés) de la Alcaldía de Baltimore recolectó muestras para volver a analizarlas luego del reciente descubrimiento de E. Coli y coliformes. Se recolectó un total de 24 especímenes y el DPW proporcionará una actualización después de que se obtengan los 24 resultados.
Además, la Oficina de Manejo de Emergencias (OEM, por sus siglas en inglés) está liderando los esfuerzos en torno a la distribución de agua a aquellos afectados por la contaminación por E. Coli y coliformes. Se distribuyeron un total de 172.000 botellas a personas que buscan ese apoyo y se continuará realizando dicha actividad.
Por su parte, el Departamento de Salud de la Ciudad de Baltimore (BCHD) continúa brindando información para ayudar a abordar las inquietudes relacionadas con este asunto. E. coli son bacterias cuya presencia indica que el agua puede estar contaminada con desechos humanos o animales. Los patógenos humanos en estos desechos pueden causar efectos a corto plazo, como diarrea, calambres, náuseas, dolores de cabeza u otros síntomas. Pueden representar un mayor riesgo para la salud de los bebés, los niños pequeños, los ancianos y las personas con sistemas inmunitarios gravemente comprometidos.